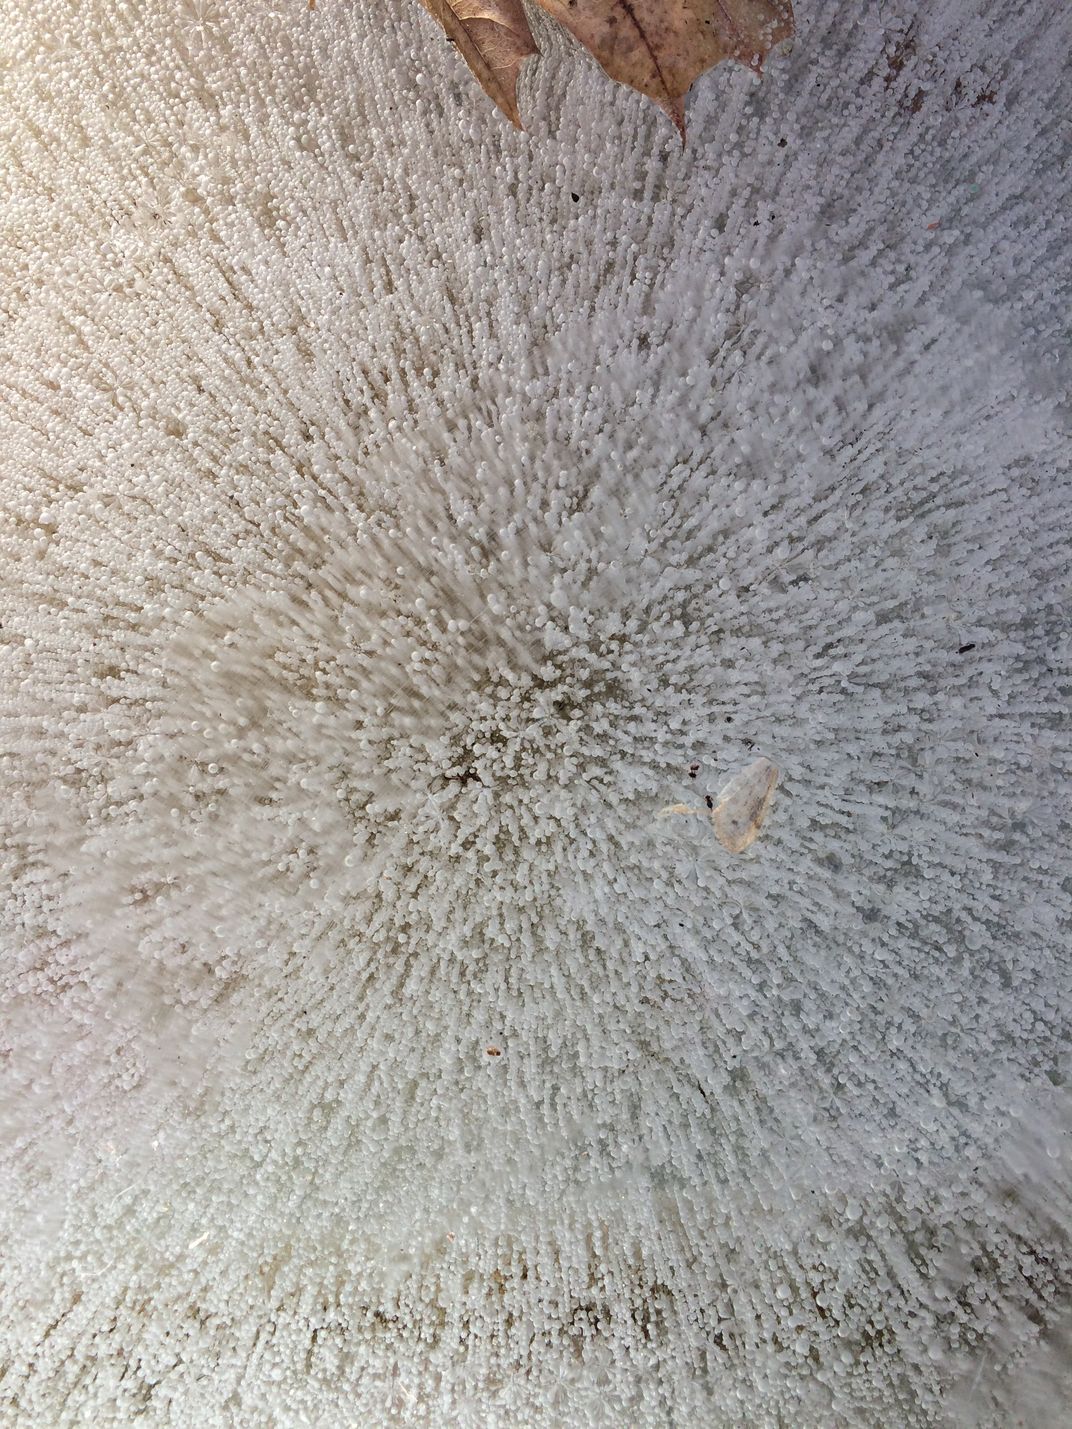

16th Annual Smithsonian Magazine Photo Contest Natural World
Time Warp
During the winter, I noticed a plastic bin that had been left outside and was filled with water and leaves. When it froze, it trapped thousands of tiny bubbles within it.
Photo Detail
| Date Taken: | 11.2017 |
| Date Uploaded: | 05.2018 |
| Photo Location: | Bridgewater, Massachusetts, United States of America |
| Camera: | iPhone 5s |
| Copyright: | © E.C. Shockley |